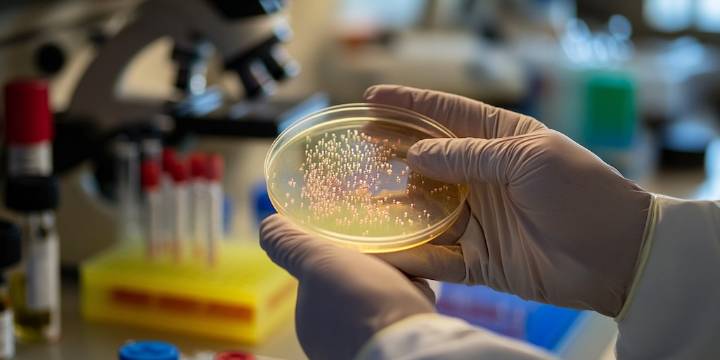
Detectan que un insecto nativo de la Antártida ingiere microplásticos

Un insecto nativo de la Antártida ha comenzado a ingerir microplásticos , según un estudio internacional liderado por la Universidad de Kentucky .
Este hallazgo, publicado en la revista Science of the Total Environment , revela que incluso en uno de los entornos más remotos y aparentemente prístinos del planeta, la contaminación plástica ha logrado infiltrarse, con potenciales consecuencias para las especies locales y, a largo plazo, para la salud de los ecosistemas polares.
En la fase final de la investigación, el equipo dirigido por Jack Devlin —quien realizó este trabajo como parte de su doctorado antes de trasladarse a Escocia como ornitólogo marino— recolectó larvas de Belgica antarctica en veinte puntos distribuidos en trece islas de la Península Antártica occi

Infobae
Bozeman Daily Chronicle Sports
Esquire